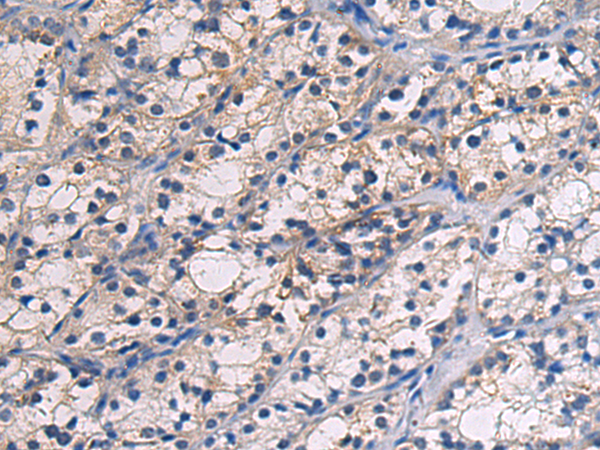

-
分类: 科研抗体货号: P13559别名:应用: IHC反应种属: Human, Mouse
-
分类: 科研抗体货号: P13540别名: GST4; GSTM; GTHMUS; GSTM2-2应用: WB,IHC反应种属: Human, Mouse
-
分类: 科研抗体货号: P13573别名: H1D; H1.3; H1F3; H1s-2; HIST1H1D应用: IHC反应种属: Human, Mouse
-
分类: 科研抗体货号: P13558别名: SMG; Sm-G应用: WB,IHC反应种属: Human, Mouse
-
分类: 科研抗体货号: P13539别名:应用: WB,IHC反应种属: Human, Rat
-
分类: 科研抗体货号: P13572别名: BDR2; DYT2应用: IHC反应种属: Human, Mouse, Rat
-
分类: 科研抗体货号: P13557别名: GNG8; GNG9; GNGT8; G-GAMMA-8; G-GAMMA-C应用: IHC反应种属: Human, Mouse
-
分类: 科研抗体货号: P13538别名: SAMS应用: IHC反应种属: Human, Mouse
-
分类: 科研抗体货号: P13556别名: ARRS2; SE70-2; ZC3H17; PRO1777; C13orf10; PPP1R132应用: IHC反应种属: Human, Mouse
-
分类: 科研抗体货号: P13571别名: hic-1; ZBTB29; ZNF901应用: IHC反应种属: Human, Mouse

鄂公网安备42018502007531号
鄂公网安备42018502007531号

